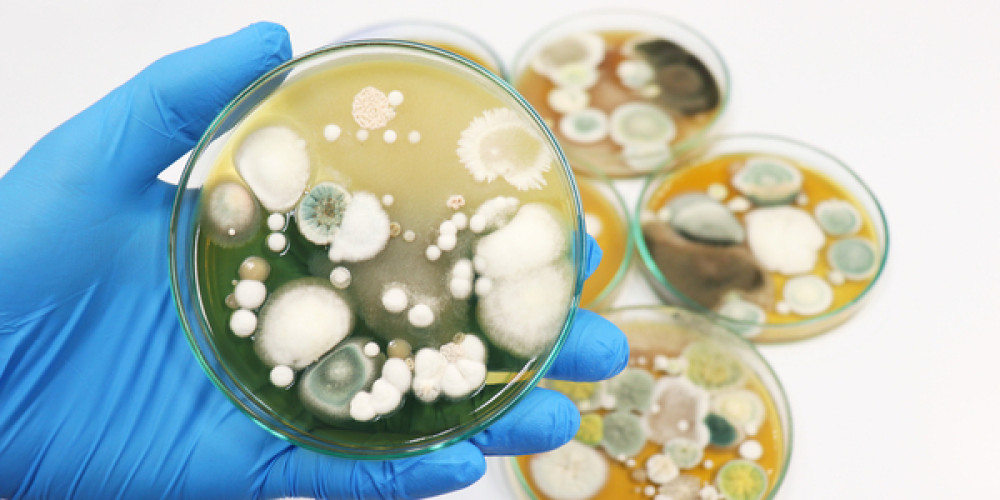

News
19.10.2020 - Kosmetik
Neue Schnellmethode zur Bestimmung von Hefen und Schimmelpilzen in Kosmetika in nur 3 Tagen
Das BAV Institut bietet ab sofort eine neue Schnellmethode zur Bestimmung der Anzahl von Hefen und Schimmelpilzen innerhalb von nur 3 Tagen in Kosmetika an. Diese Untersuchung wird bislang bei Lebensmitteln und ab sofort ebenfalls bei Kosmetika durchgeführt.
Nach dem bisher angewandtem ISO-Referenzverfahren liegen die Ergebnisse der Hefen und Schimmelpilze nach 5 Tagen vor (ISO 16212), die der Bakterien nach 3 Tagen (ISO 21149). Fortan haben Sie die Möglichkeit, zwischen den ISO-Verfahren sowie unserer validierten und akkreditierten Schnellmethode zu wählen. Bei Anwendung der Schnellmethode liegen alle Ergebnisse der mikrobiologischen Prüfung von Kosmetika vollständig nach 3 Tagen vor, was eine enorme Zeitersparnis mit sich bringt.
Weitere Informationen finden Sie in unserem Newsletter .
Profitieren auch Sie von der Schnellmethode! Sprechen Sie uns gerne an, wir erstellen Ihnen ein Angebot hierzu. Die Kundenberater freuen sich über Ihren Anruf.